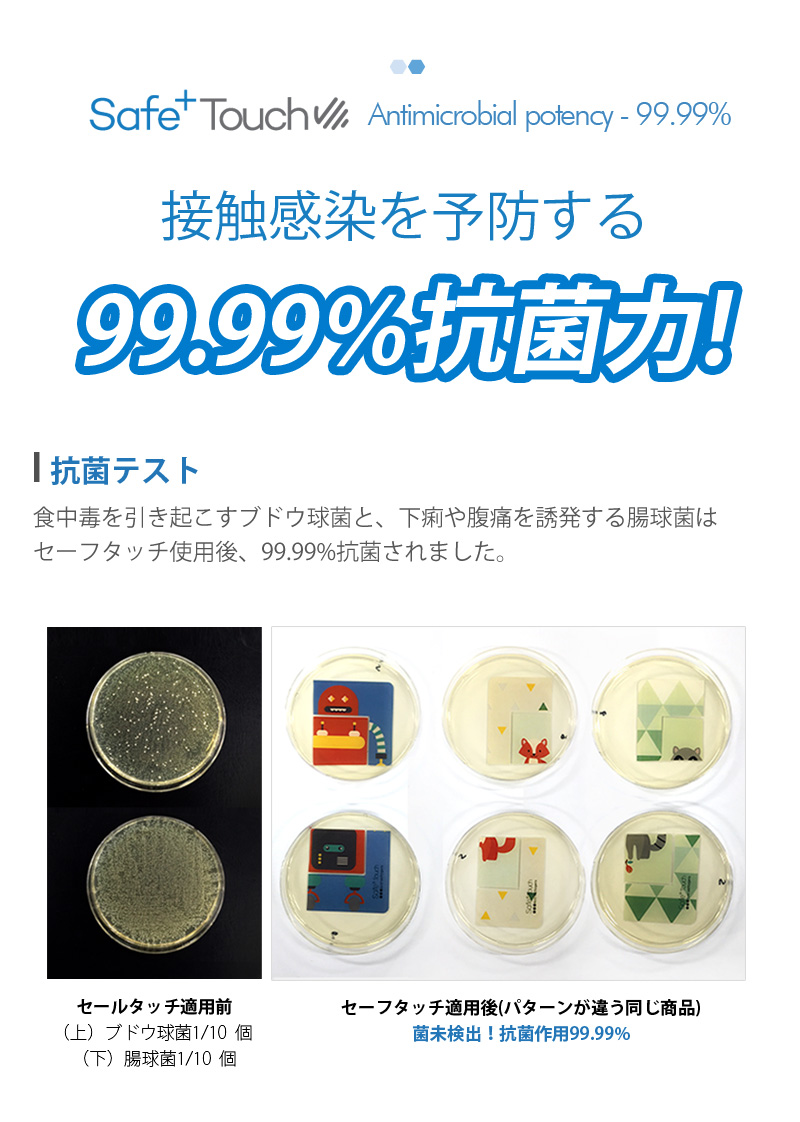

セーフタッチ 抗菌テープ (透明タイプ)

| 商品名 | セーフタッチ 抗菌テープ |
| サイズ | 幅33cm x 長さ3m |
| 原産国 | KOREA |
| タイプ | Anti-pathogenic Tape |
| 注意事項 |
※必ずお読みください! ・すべてのウイルスに除菌、抗菌効果があるわけではありません。 ・手袋やマスクと違ってシートの設置場所やシートへの触り方等、・状況ごとに効果に差異があることを予めご了承ください。 ・透明ではありますが、繰り返し印刷されているロゴが多数ありますので、邪魔になる可能性があります。予めご了承の上でご購入してください。 ・全てのタッチパネルで動作を保証するものではありません。タッチパネルが反応しないことによるキャンセル、返品はできません。 ・お使いの環境や日数によって抗菌効果は変化します。 ・凹凸のある場所では貼り付けができません。ご注意ください。 ・素材によっては貼り付けできない場合があります。予めご注意ください。 ・素材によって剥がした跡にシール跡が残ってしまう可能性があります。予めご了承の上でご購入ください。 |














